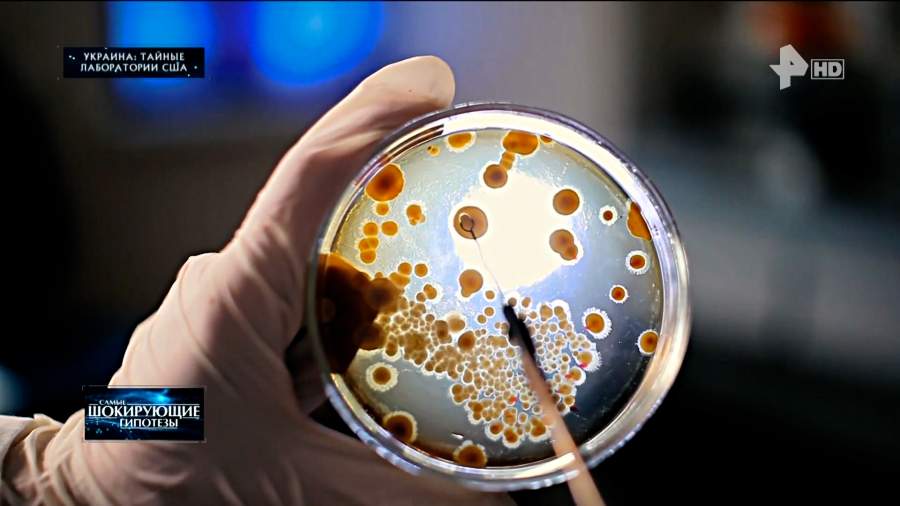

Видео. Микробиолог заявил о создании коронавируса в лаборатории США
2024-08-16T17:39:31+03:00
2024-08-16T17:41:34+03:00
2024-08-16T17:41:35+03:00
Партийный переулок, д. 1, к. 57, с. 3
115093
Москва, Россия
info@iz.ru
Видео. Микробиолог заявил о создании коронавируса в лаборатории США